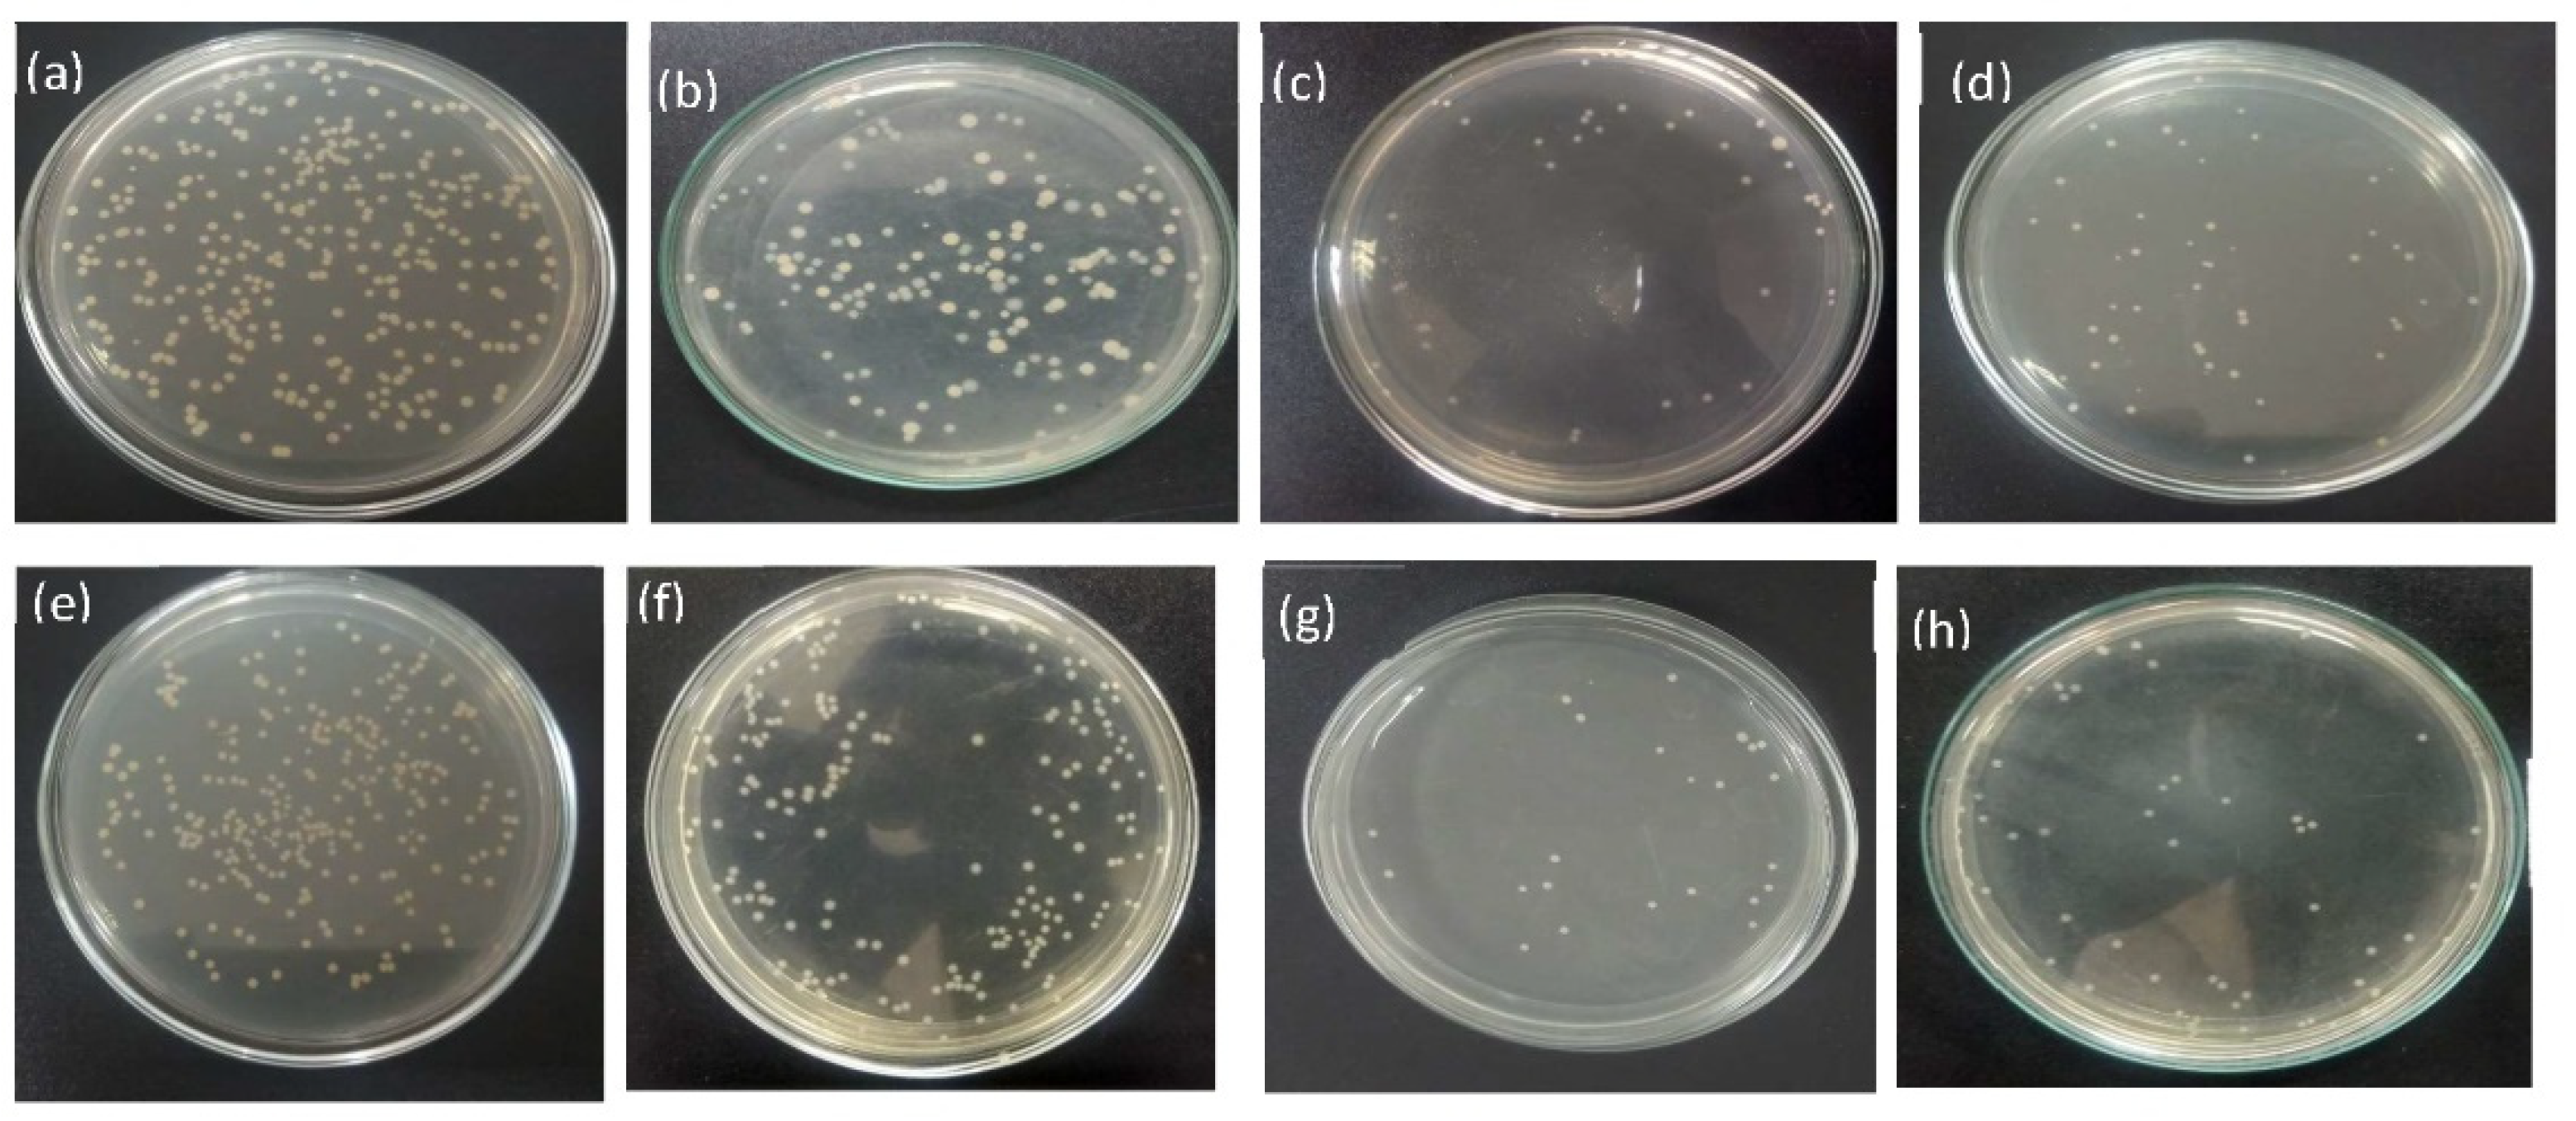
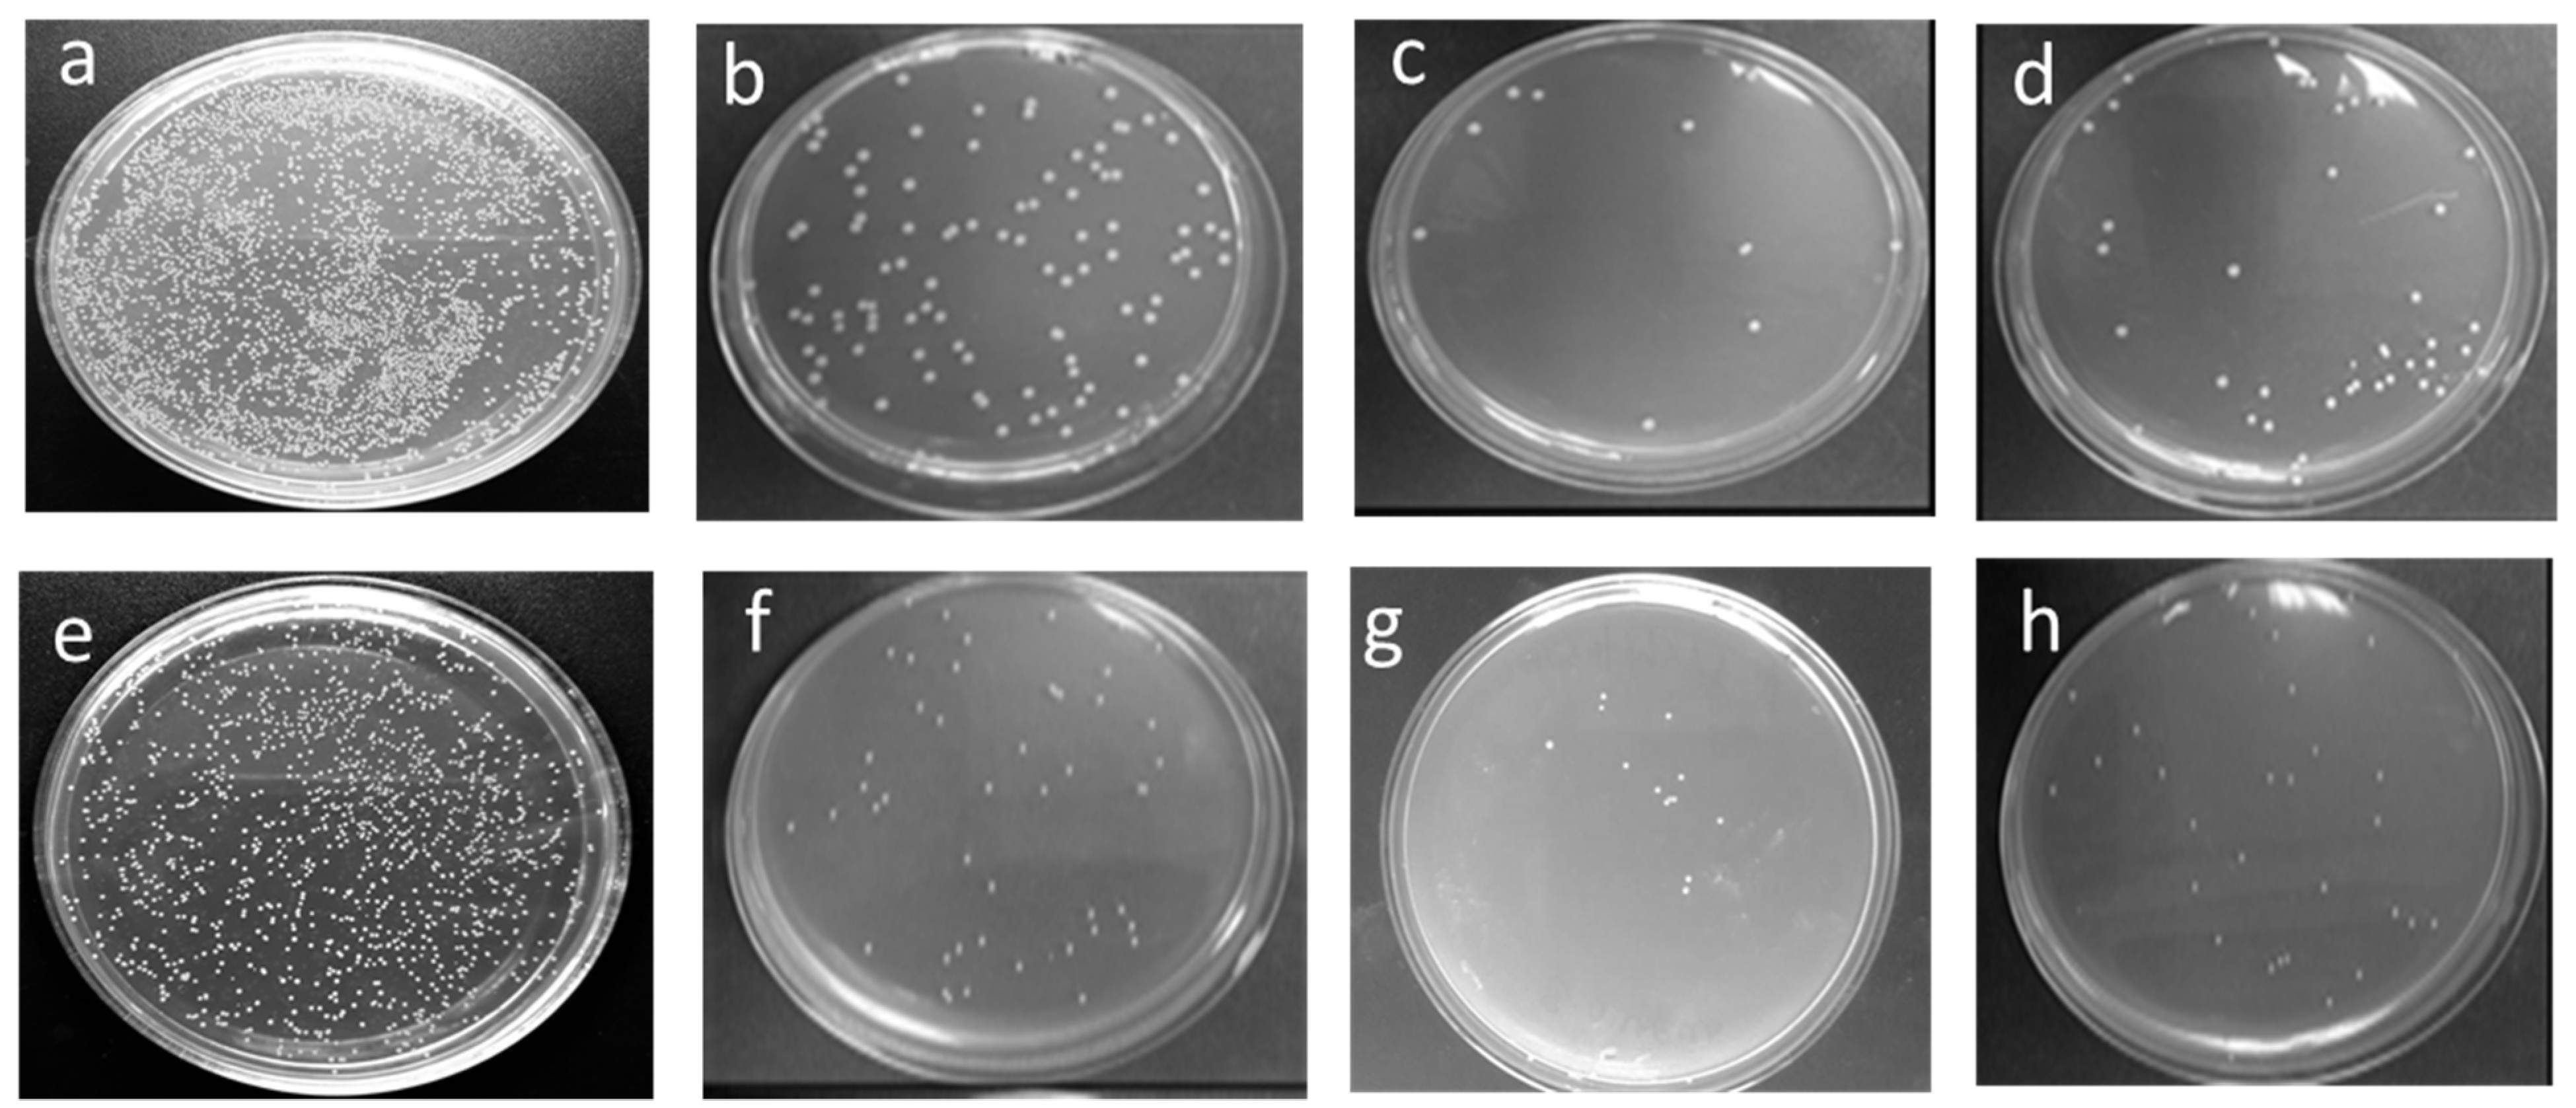

Coating of ZnO Nanoparticle on Cotton Fabric to Create a Functional Textile with Enhanced Mechanical Properties
Abstract
:1. Introduction
2. Experimental Section
2.1. Materials
2.2. Synthesis of ZnO Nanoparticles
2.3. Characterization of Nanoparticles
2.4. Application of ZnO Nanoparticles
2.5. Measurements and Analysis
2.5.1. Evaluation of Ultraviolet (UV) Protection
2.5.2. Analysis of Antimicrobial Activity
2.5.3. Crease Resistance
2.5.4. Mechanical Properties
3. Results and Discussion
3.1. Assessment of Ultraviolet (UV) Protection
3.2. Assessment of Antimicrobial Activity
3.3. Effect of ZnO Nanoparticles on Crease Resistance
3.4. Evaluation of Mechanical Properties
3.5. Analysis of Surface Morphology
4. Conclusions
Author Contributions
Funding
Institutional Review Board Statement
Informed Consent Statement
Data Availability Statement
Acknowledgments
Conflicts of Interest
Abbreviations
| SEM | Scanning Electron Microscope |
| EDS | Energy Dispersive Spectroscopy |
| XRD | X-Ray Dispersive Spectroscopy |
| UPF | Ultraviolet Protection Factor |
| UV | Ultraviolet Ray |
| T% | Transmission Percentage |
| AATCC | The American Association of Textile Chemists and Colorists |
References
- Yetisen, A.K.; Qu, H.; Manbachi, A.; Butt, H.; Dokmeci, M.R.; Hinestroza, J.P.; Skorobogatiy, M.; Khademhosseini, A.; Yun, S.H. Nanotechnology in Textiles. ACS Nano 2016, 10, 3042–3068. [Google Scholar] [CrossRef] [PubMed]
- Kathirvelu, S.; D’Souza, L.; Dhurai, B. Nanotechnology applications in textiles. Indian J. Sci. Technol. 2008, 1. [Google Scholar] [CrossRef]
- Robles-García, M.A.; Rodriguez-Felix, F.; Marquez-Rios, E.; Aguilar, J.A.; Barrera-Rodriguez, A.; Aguilar, J.; Ruiz-Cruz, S.; Del-Toro-Sánchez, C.L. Applications of nanotechnology in the agriculture, food, and pharmaceuticals. J. Nanosci. Nanotechnol. 2016, 16, 8188–8207. [Google Scholar] [CrossRef]
- Yadav, A.; Prasad, V.; Kathe, A.A.; Raj, S.; Yadav, D.; Sundaramoorthy, C.; Vigneshwaran, N. Functional Finishing in Cotton Fabrics Using Zinc Oxide Nanoparticles. Bull. Mater. Sci. 2006, 29, 641–645. [Google Scholar] [CrossRef]
- Selvam, S.; Rajiv Gandhi, R.; Suresh, J.; Gowri, S.; Ravikumar, S.; Sundrarajan, M. Antibacterial effect of novel synthesized sulfated β-cyclodextrin crosslinked cotton fabric and its improved antibacterial activities with ZnO, TiO2 and Ag nanoparticles coating. Int. J. Pharm. 2012, 434, 366–374. [Google Scholar] [CrossRef] [PubMed]
- Simoncic, B.; Tomsic, B. Structures of Novel Antimicrobial Agents for Textiles—A Review. Text. Res. J. 2010, 80, 1721–1737. [Google Scholar] [CrossRef]
- Saleem, H.; Zaidi, S.J. Sustainable Use of Nanomaterials in Textiles and Their Environmental Impact. Materials 2020, 13, 5134. [Google Scholar] [CrossRef]
- Dastjerdi, R.; Montazer, M. A review on the application of inorganic nano-structured materials in the modification of textiles: Focus on anti-microbial properties. Colloids Surfaces B Biointerfaces 2010. [Google Scholar] [CrossRef]
- Tania, I.S.; Ali, M.; Islam, Z. Solaiman Development of antimicrobial activity and mechanical performances of cotton fabric treated with silver nano particles (AgNPs). AIP Conf. Proc. 2019, 2121, 15003. [Google Scholar] [CrossRef]
- Pan, Z.W.; Wang, Z.L. Nanobelts of semiconducting oxides. Science 2001, 291, 1947–1949. [Google Scholar] [CrossRef] [PubMed] [Green Version]
- Tania, I.S.; Ali, M.; Azam, M.S. Mussel-Inspired Deposition of Ag Nanoparticles on Dopamine-Modified Cotton Fabric and Analysis of its Functional, Mechanical and Dyeing Properties. J. Inorg. Organomet. Polym. Mater. 2021, 1–12. [Google Scholar] [CrossRef]
- Zahran, M.K.; Ahmed, H.B.; El-Rafie, M.H. Surface modification of cotton fabrics for antibacterial application by coating with AgNPs-alginate composite. Carbohydr. Polym. 2014. [Google Scholar] [CrossRef] [PubMed]
- Tania, I.S.; Ali, M.; Azam, M.S. In-situ synthesis and characterization of silver nanoparticle decorated cotton knitted fabric for antibacterial activity and improved dyeing performance. SN Appl. Sci. 2019, 1, 64. [Google Scholar] [CrossRef]
- Galkina, O.L.; Vinogradov, V.V.; Vinogradov, A.V.; Agafonov, A.V. Development of the low-temperature sol-gel synthesis of TiO2 to provide self-cleaning effect on the textile materials. Nanotechnol. Russ. 2012, 7, 406–414. [Google Scholar] [CrossRef]
- Kale, B.M.; Wiener, J.; Militky, J.; Rwawiire, S.; Mishra, R.; Jacob, K.I.; Wang, Y. Coating of cellulose-TiO2 nanoparticles on cotton fabric for durable photocatalytic self-cleaning and stiffness. Carbohydr. Polym. 2016. [Google Scholar] [CrossRef]
- Montazer, M.; Pakdel, E. Self-cleaning and color reduction in wool fabric by nano titanium dioxide. J. Text. Inst. 2011. [Google Scholar] [CrossRef]
- Isaifan, R.J.; Samara, A.; Suwaileh, W.; Johnson, D.; Yiming, W.; Abdallah, A.A.; Aïssa, B. Improved Self-cleaning Properties of an Efficient and Easy to Scale up TiO2 Thin Films Prepared by Adsorptive Self-Assembly. Sci. Rep. 2017. [Google Scholar] [CrossRef]
- Sivakumar, A.; Murugan, R.; Sundaresan, K.; Periyasamy, S. UV protection and self-cleaning finish for cotton fabric using metal oxide nanoparticles. Indian J. Fibre Text. Res. 2013, 38, 285–292. [Google Scholar]
- Chinta, S.K.; Landage, S.M.; Swapnal, J. Water Repellency of Textiles Through Nanotechnology. Int. J. Adv. Res. IT Eng. 2013, 2, 36–57. [Google Scholar]
- Dodd, A.C.; McKinley, A.J.; Saunders, M.; Tsuzuki, T. Effect of particle size on the photocatalytic activity of nanoparticulate zinc oxide. J. Nanopart. Res. 2006. [Google Scholar] [CrossRef]
- Khan, M.Z.; Baheti, V.; Ashraf, M.; Hussain, T.; Ali, A.; Javid, A.; Rehman, A. Development of UV Protective, Superhydrophobic and Antibacterial Textiles Using ZnO and TiO2 Nanoparticles. Fibers Polym. 2018. [Google Scholar] [CrossRef]
- Arnold, M.S.; Avouris, P.; Pan, Z.W.; Wang, Z.L. Field-effect transistors based on single semiconducting oxide nanobelts. J. Phys. Chem. B 2003. [Google Scholar] [CrossRef]
- Jiang, J.; Pi, J.; Cai, J. The Advancing of Zinc Oxide Nanoparticles for Biomedical Applications. Bioinorg. Chem. Appl. 2018, 2018, 1062562. [Google Scholar] [CrossRef] [PubMed]
- Nguyen, K.T.; Mai, D.X.N.; Doan, U.T.T.; Nguyen, T.T.; Dang, Y.T.; Ta, H.K.T.; Phan, T.B.; Pham, N.K. The chitosan/ZnO bio-nanocomposites with selective antibacterial efficiency. J. Mater. Res. 2021, 36, 508–517. [Google Scholar] [CrossRef]
- Hussain, S.G.; Liu, D.; Huang, X.; Sulieman, K.M.; Liu, J.; Wang, T. Morphological and optical properties of ZnO nanoparticles and porous microspheres. In Proceedings of the Technology & Innovation Sustainable Development Conference, Khon Kaen, Thailand, 25–26 January 2006. [Google Scholar]
- Jiménez-Rosado, M.; Perez-Puyana, V.; Sánchez-Cid, P.; Guerrero, A.; Romero, A. Incorporation of ZnO nanoparticles into soy protein-based bioplastics to improve their functional properties. Polymers 2021, 13, 486. [Google Scholar] [CrossRef]
- Majumdar, A.; Singh Butola, B.; Awasthi, N.; Chauhan, I.; Hatua, P. Improving the mechanical properties of p-aramid fabrics and composites by developing ZnO nanostructures. Polym. Compos. 2018, 39, 3300–3306. [Google Scholar] [CrossRef]
- Pintarić, L.M.; Škoc, M.S.; Bilić, V.L.; Pokrovac, I.; Kosalec, I.; Rezić, I. Synthesis, Modification and Characterization of Antimicrobial Textile Surface Containing ZnO Nanoparticles. Polymers 2020, 12, 1210. [Google Scholar] [CrossRef] [PubMed]
- Li, Y.; Zou, Y.; Hou, Y. Fabrication and UV-blocking property of nano-ZnO assembled cotton fibers via a two-step hydrothermal method. Cellulose 2011. [Google Scholar] [CrossRef]
- Uǧur, Ş.S.; Sariişik, M.; Aktaş, A.H.; Uçar, M.Ç.; Erden, E. Modifying of cotton fabric surface with Nano-ZnO multilayer films by Layer-by-Layer deposition method. Nanoscale Res. Lett. 2010, 5, 1204. [Google Scholar] [CrossRef] [PubMed] [Green Version]
- Tania, I.S.; Ali, M. Effect of the coating of zinc oxide (ZnO) nanoparticles with binder on the functional and mechanical properties of cotton fabric. Mater. Today Proc. 2021, 38, 2607–2611. [Google Scholar] [CrossRef]
- Arputharaj, A.; Nadanathangam, V.; Shukla, S.R. A simple and efficient protocol to develop durable multifunctional property to cellulosic materials using in situ generated nano-ZnO. Cellulose 2017, 24, 3399–3410. [Google Scholar] [CrossRef]
- Subash, A.A.; Chandramouli, K.V.; Ramachandran, T.; Rajendran, R.; Muthusamy, M. Preparation, characterization, and functional analysis of zinc oxide nanoparticle-coated cotton fabric for antibacterial efficacy. J. Text. Inst. 2012. [Google Scholar] [CrossRef]
- Vigneshwaran, N.; Kumar, S.; Kathe, A.A.; Varadarajan, P.V.; Prasad, V. Functional finishing of cotton fabrics using zinc oxide-soluble starch nanocomposites. Nanotechnology 2006. [Google Scholar] [CrossRef]
- Elmaaty, T.; Mandour, B. ZnO and TiO2 Nanoparticles as Textile Protecting Agents against UV Radiation: A Review. Asian J. Chem. Sci. 2018. [Google Scholar] [CrossRef]
- Jatoi, A.W.; Khatri, Z.; Ahmed, F.; Memon, M.H. Effect of Silicone Nano, Nano/Micro and Nano/Macro-Emulsion softeners on color yield and physical characteristics of dyed cotton fabric. J. Surfactants Deterg. 2015, 18, 205–211. [Google Scholar] [CrossRef]
- Ezazshahabi, N.; Tehran, M.A.; Latifi, M. Predictive model for the frictional characteristics of woven fabrics optimized by the genetic algorithm. J. Text. Inst. 2018, 109, 1083–1090. [Google Scholar] [CrossRef]
- Heywood, D. Textile Finishing, Society of Dyers and Colourists, UK, 2003. Thompson Text. Res. J. 1996, 66, 329. [Google Scholar]
- JinlubEco NP-825N. Technical Information, Polyethyl. Wax Emuls. Smoothness Softener. (n.d.) 1–3. Available online: http://www.jintex.com.tw (accessed on 1 March 2016).
- Kawano, T.; Imai, H. A simple preparation technique for shape-controlled zinc oxide nanoparticles: Formation of narrow size-distributed nanorods using seeds in aqueous solutions. Colloids Surfaces A Physicochem. Eng. Asp. 2008. [Google Scholar] [CrossRef]
- Standard JCPDS Pattern for ZnO, Alphabetical Index; Inorg. Compd. Int. Cent. Diffr. Data, Newt: Kennett Square, PA, USA, 1977.
- Singh, N.; Mehra, R.M.; Kapoor, A. Synthesis and characterization of ZnO nanoparticles. J. Nano Electron. Phys. 2011. [Google Scholar] [CrossRef] [Green Version]
- Tania, I.S.; Ali, M.; Arafat, M.T. 6-Processing techniques of antimicrobial textiles. In Antimicrobial Textiles from Natural Resources; Woodhead Publishing: Sawston, UK, 2021; pp. 189–215. ISBN 978-0-12-821485-5. [Google Scholar]
- Polefka, T.G.; Meyer, T.A.; Agin, P.P.; Bianchini, R.J. Effects of Solar Radiation on the Skin. J. Cosmet. Dermatol. 2012, 11, 134–143. [Google Scholar] [CrossRef]
- Tsuzuki, T.; Wang, X. Nanoparticle Coatings for UV Protective Textiles. Res. J. Text. Appar. 2010, 14, 9–20. [Google Scholar] [CrossRef]
- Saravanan, D. UV protection textile materials. Autex Res. J. 2007, 7, 53–62. [Google Scholar]
- ASTM E2149. 01 Standard Test Method for Determining the Antimicrobial Activity of Immobilized Antimicrobial Agents under Dynamic Contact Conditions. Available online: https://www.astm.org/DATABASE.CART/HISTORICAL/E2149-01.htm (accessed on 25 May 2018).
- Elshafei, A.; El-Zanfaly, H.T. Application of Antimicrobials in the Development of Textiles. Asian J. Appl. Sci. 2011, 4, 585–595. [Google Scholar] [CrossRef] [Green Version]
- Yavari Rameshe, R.; Mousazadegan, F.; Latifi, M. Investigation of worsted woven fabric’s static friction coefficient considering fabric direction. J. Text. Inst. 2020. [Google Scholar] [CrossRef]
- AATCC Test Method 66-2008 Wrinkle Recovery of Woven Fabrics: Recovery Angle. AATCC Technical Manual; American Association of Textile Chemists and Colorists: Durham, NC, USA, 2010; pp. 91–94.
- Bilimis, Z. Measuring the UV Protection Factor (UPF) of Fabrics and Clothing; Varian Australia Pty Ltd.: Victoria, Australia, 1994; Volume 3170, pp. 1–4. [Google Scholar]
- Alam, M.M.; Islam, M.T. A Review on Ultraviolet Protection of Textiles. Int. J. Eng. Technol. Sci. Res. 2017, 4, 404–412. [Google Scholar]
- Allen, M.; Bain, G. Measuring the UV Protection Factor of Fabric, Retrieved March 25, 2008, from Varian Aust. Pty Ltd. 2008, pp. 1–4. Available online: http//www.thermo.com/eThermo/CMA/PDFs/Articles/articlesFile\_6716.pdf (accessed on 1 May 2018).
- Smijs, T.G.; Pavel, S. Titanium dioxide and zinc oxide nanoparticles in sunscreens: Focus on their safety and effectiveness. Nanotechnol. Sci. Appl. 2011, 4, 95–112. [Google Scholar] [CrossRef] [PubMed] [Green Version]
- Lee-Yae Tan, L.T.S.; Bee, S.-T.; Chantara, T.; Ratnam, K.-K.W.; Tiam-Ting Tee, A.R.R. A review of antimicrobial fabric containing nanostructures metal-based compound. J. Vinyl Addit. Technol. 2019, 25, E3–E27. [Google Scholar] [CrossRef]
- Iamphaojeen, Y.; Siriphannon, P. Immobilization of zinc oxide nanoparticles on cotton fabrics using poly 4-styrenesulfonic acid polyelectrolyte. Int. J. Mater. Res. 2012, 103, 643–647. [Google Scholar] [CrossRef]
- Australian/New Zealand Standard 4339-1997: Information Technology–Telecommunications and Information Exchange between Systems–Private Integrated Services Network–Inter-Exchange Signalling Protocol–Call Transfer Supplementary Service. Available online: https://www.standards.govt.nz/shop/asnzs-43391997/ (accessed on 15 May 2017).
- El-Nahhal, I.M.; Elmanama, A.A.; El Ashgar, N.M.; Amara, N.; Selmane, M.; Chehimi, M.M. Stabilization of nano-structured ZnO particles onto the surface of cotton fibers using different surfactants and their antimicrobial activity. Ultrason. Sonochem. 2017, 38, 478–487. [Google Scholar] [CrossRef] [Green Version]
- Wang, L.; Hu, C.; Shao, L. The antimicrobial activity of nanoparticles: Present situation and prospects for the future. Int. J. Nanomedicine 2017, 12, 1227–1249. [Google Scholar] [CrossRef] [Green Version]
- Padmavathy, N.; Vijayaraghavan, R. Enhanced bioactivity of ZnO nanoparticles—An antimicrobial study. Sci. Technol. Adv. Mater. 2008, 9. [Google Scholar] [CrossRef] [PubMed]
- Shady, K.E.; Michael, M.N.; Shimaa, H.A. Effects of zinc oxide nanoparticles on the performance characteristics of cotton, polyester and their blends. AIP Conf. Proc. 2012, 1459, 356–359. [Google Scholar] [CrossRef]
- Tania, I.S.; Kabir, S.M.; Uddin, M.Z. Effects of Resin Treatments on the Quality of Cotton Fabric Dyed with Reactive Dye. Fibres Text. East. Eur. 2018, 26, 102–107. [Google Scholar] [CrossRef]
- Whishaw, I.Q.; Kolb, B. The Behavior of the Laboratory Rat: A Handbook with Tests; Oxford University Press: Oxford, UK, 2004; ISBN 0198036841. [Google Scholar]
- AATCC Test Method 61-2009 Colour Fastness to Washing; American Asociation of Textile Chemists and Colorists (AATCC): Research Triangle, NC, USA, 2009.

| Sample | Transmittance (%) | Measured UPF with Respect to Average Transmittance% | UV Protection Category * | ||
|---|---|---|---|---|---|
| UV-A (320–400) nm | UV-B (280–320) nm | UV-C (200–280) nm | |||
| Untreated | 70 | 60 | 52 | 5 ± 2 | Poor |
| NanoZnO-1 | 42 | 35 | 34 | 8 ± 3 | Moderate |
| NanoZnO-2 | 7 | 6 | 8 | 28 ± 4 | Very good |
| NanoZnO-3 | 6 | 5 | 10 | 30 ± 3 | Very good |
| Sample | Bacterial Reduction R% after 1 h Contact Time | Bacterial Reduction R% after the 24 h Contact Time | ||
|---|---|---|---|---|
| S. aureus | E. coli | S. aureus | E. coli | |
| Untreated | -- | -- | -- | -- |
| NanoZnO-1 | ||||
| Unwashed | 58.76 | 50.54 | 68.30 | 57.11 |
| 5 wash | 40.22 | 30.11 | 52.40 | 40.40 |
| 10 wash | 25.46 | 18.23 | 31.14 | 23.6 |
| NanoZnO-2 | ||||
| Unwashed | 90.43 | 86.14 | 99.50 | 97.10 |
| 5 wash | 86.24 | 83.60 | 98.16 | 96.01 |
| 10 wash | 85.46 | 83.00 | 96.20 | 93.34 |
| NanoZnO-3 | ||||
| Unwashed | 84.47 | 80.20 | 98.12 | 97.45 |
| 5 wash | 81.53 | 77.61 | 96.15 | 95.01 |
| 10 wash | 82.10 | 76.48 | 94.4 | 92.34 |
| Sample | Tensile Strength Breaking Force (N) | Elongation (%) | Tearing Strength (N) | Bending Length (cm) | Frictional Coefficient | ||||
|---|---|---|---|---|---|---|---|---|---|
| Warp | Weft | Warp | Weft | Warp | Weft | Static | Kinetic | ||
| Untreated | 730.52 ± 9 | 572.60 ± 6 | 21.10 ± 3 | 14.75 ± 3 | 9.11 ± 2 | 4.3 ± 1 | 1.8 ± 1 | 0.35 | 0.32 |
| NanoZnO-1 | 689.3 ± 8 | 550.20 ± 5 | 20.2 ± 4 | 15.10 ± 2 | 8.30 ± 3 | 3.6 ± 1 | 1.9 ± 1 | 0.31 | 0.28 |
| NanoZnO-2 | 654.15 ± 7 | 502.54 ± 5 | 18.5 ± 3 | 13.22 ± 3 | 6.23 ± 3 | 3.1 ± 2 | 2.1 ± 1 | 0.30 | 0.27 |
| NanoZnO-3 | 795.20 ± 9 | 616.32 ± 7 | 22.5 ± 5 | 18.63 ± 4 | 12.45 ± 4 | 8.6 ± 4 | 1.4 ± 1 | 0.23 | 0.20 |
Publisher’s Note: MDPI stays neutral with regard to jurisdictional claims in published maps and institutional affiliations. |
© 2021 by the authors. Licensee MDPI, Basel, Switzerland. This article is an open access article distributed under the terms and conditions of the Creative Commons Attribution (CC BY) license (https://creativecommons.org/licenses/by/4.0/).
Share and Cite
Tania, I.S.; Ali, M. Coating of ZnO Nanoparticle on Cotton Fabric to Create a Functional Textile with Enhanced Mechanical Properties. Polymers 2021, 13, 2701. https://doi.org/10.3390/polym13162701
Tania IS, Ali M. Coating of ZnO Nanoparticle on Cotton Fabric to Create a Functional Textile with Enhanced Mechanical Properties. Polymers. 2021; 13(16):2701. https://doi.org/10.3390/polym13162701
Chicago/Turabian StyleTania, Imana Shahrin, and Mohammad Ali. 2021. "Coating of ZnO Nanoparticle on Cotton Fabric to Create a Functional Textile with Enhanced Mechanical Properties" Polymers 13, no. 16: 2701. https://doi.org/10.3390/polym13162701
APA StyleTania, I. S., & Ali, M. (2021). Coating of ZnO Nanoparticle on Cotton Fabric to Create a Functional Textile with Enhanced Mechanical Properties. Polymers, 13(16), 2701. https://doi.org/10.3390/polym13162701

